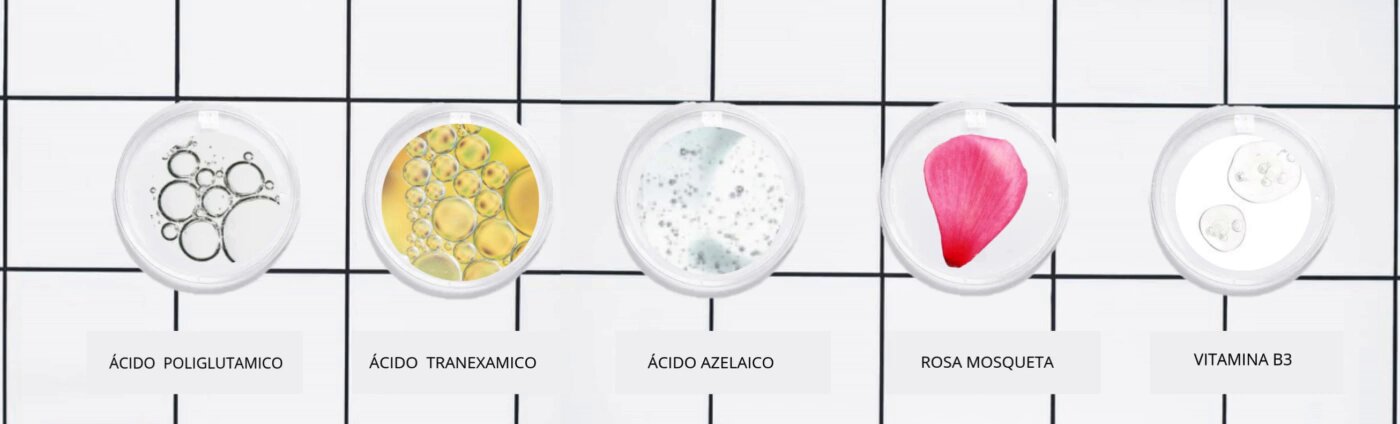

SERUM ACIDO AZELAICO & TRANEXAMICO 30 ML
Cuida delicadamente la piel, seborregula y mejora la piel grasa controlando y previniendo la acumulacción bacteriana. Remueve manchas oscuras, es suave pero eficaz para pieles sensibles. Su textura proporciona bienestar mejora el tono; experimenta el cuidado de nuestros componentes a base de plantas y ácidos frutales suaves que reducen la hiperpigmentación proporcionan nutrición activan la producción de colágeno e igualan tu tono de piel.

Testimonios
Preguntas frecuentes
-
Sí, nuestros productos están formulados con ingredientes suaves y naturales que son adecuados para pieles sensibles.
-
Sí, ofrecemos productos específicos para piel grasa y mixta que ayudan a controlar el acné y mejorar la apariencia de la piel.
-
Sí, en Sole Paris nos comprometemos a no realizar pruebas en animales y todos nuestros productos son cruelty-free.
-
Sí, nuestros productos están diseñados para ser complementarios, por lo que puedes combinar diferentes líneas según las necesidades de tu piel y cabello.